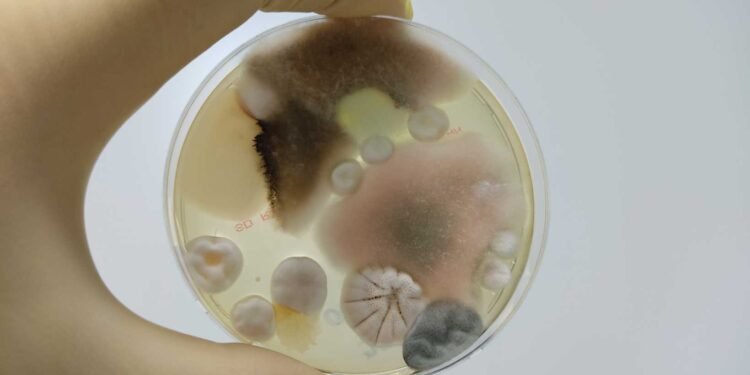
Accuracy Matters: Evaluating the Effectiveness of DIY Mold Tests Against Professional Standards

DIY mold testing kits have become increasingly popular in recent years, offering a cost-effective and convenient solution for homeowners who suspect they may have a mold problem. However, the accuracy of these kits has been called into question, with some experts warning that they may not be as effective as professional mold inspections.
Mold is a common problem in homes and can have serious health implications, including respiratory problems, allergies, and skin irritation. It is important to identify and address mold growth as soon as possible to prevent further damage to your home and protect your health. DIY mold test kits offer a quick and easy way to test for mold, but their accuracy is often called into question.
In this article, we will delve into the science of mold and its health implications, provide an overview of DIY mold test kits and professional mold inspections, and explore the comparative analysis of DIY vs. professional testing. We will also discuss how to identify and assess mold in your home, interpret test results, and take the necessary next steps to address any mold problems. Additionally, we will examine the role of environmental conditions in mold proliferation and the regulations and standards for mold testing. Finally, we will answer some frequently asked questions about mold testing.
Key Takeaways
- DIY mold test kits offer a cost-effective and convenient solution for homeowners who suspect they may have a mold problem, but their accuracy is often called into question.
- Professional mold inspections provide expertise, specialized equipment, and the ability to assess hidden areas, but can be more expensive than DIY kits.
- Identifying and addressing mold growth as soon as possible is crucial to prevent further damage to your home and protect your health.
The Science of Mold and Health Implications
Mold is a type of fungus that can grow both indoors and outdoors. It thrives in moist environments and can be found in various forms, including black, white, green, and orange. Mold spores are microscopic, and they can spread through the air or attach themselves to objects, making it difficult to detect them with the naked eye.
Understanding Mold Growth and Exposure
Mold growth can occur in any area with moisture, such as bathrooms, kitchens, and basements. It can grow on various surfaces, including wood, paper, carpet, and food. Mold spores can be released into the air when disturbed, such as during cleaning or renovation activities.
Exposure to mold can cause a range of health problems, depending on the individual’s sensitivity and the duration of exposure. Some people may experience no symptoms, while others may develop allergic reactions or respiratory problems. The severity of symptoms can vary from mild to severe, and they can be acute or chronic.
Health Risks Associated with Mold
Exposure to mold can cause a range of health problems, including allergies, asthma, and other respiratory problems. Some people may also experience skin irritation, eye irritation, and headaches. Individuals with weakened immune systems, such as the elderly and young children, may be at a higher risk of developing severe health problems from mold exposure.
According to a study published in the Journal of Allergy and Clinical Immunology [1], exposure to mold can exacerbate existing respiratory conditions, such as asthma. The study found that individuals who were exposed to mold had a higher risk of developing asthma symptoms, such as wheezing and coughing.
In conclusion, mold growth can be a serious health hazard, and it is essential to take appropriate measures to prevent and control it. Individuals who suspect mold growth in their homes or workplaces should seek professional assistance to assess the extent of the problem and determine the appropriate course of action.
[1] The medical effects of mold exposure
DIY Mold Test Kits: An Overview
Mold is a common problem in households and can cause serious health issues. To detect mold, people can choose between professional mold testing services and do-it-yourself (DIY) mold test kits. DIY mold test kits are affordable and convenient, but their accuracy is often questioned. This section will provide an overview of DIY mold test kits, their types, usage, and limitations.
Types and Usage of Mold Test Kits
DIY mold test kits come in two main types: surface test kits and air test kits. Surface test kits are used to test visible mold on surfaces, while air test kits are used to detect airborne mold spores. Both types of kits come with instructions on how to collect samples and send them to a lab for analysis.
Surface test kits usually include swabs, tapes, or petri dishes to collect samples. The collected samples are then sent to a lab for analysis to identify the type and concentration of mold. Surface test kits are easy to use and can detect visible mold, but they may not detect hidden mold.
Air test kits usually include a pump and a collection device to collect air samples. The collected samples are then sent to a lab for analysis to count the number of mold spores in the air. Air test kits can detect hidden mold and airborne mold spores, but they require more expertise to use correctly.
Limitations of DIY Mold Testing
DIY mold test kits have several limitations that can affect their reliability. First, DIY mold test kits are not as accurate as professional mold testing services. According to the Environmental Protection Agency (EPA), “sampling for mold should be conducted by professionals who have specific experience in designing mold sampling protocols, sampling methods, and interpreting results.”
Second, DIY mold test kits may not detect all types of mold. There are over 100,000 types of mold, and DIY mold test kits may only detect a few of them. This can lead to false negatives, where the test kit does not detect mold that is present.
Third, DIY mold test kits may not detect hidden mold. Hidden mold is mold that is not visible on surfaces and can grow inside walls, ceilings, or floors. DIY mold test kits may not be able to detect hidden mold, which can lead to inaccurate results.
In conclusion, while DIY mold test kits are affordable and convenient, their accuracy is often questioned. People should consider the limitations of DIY mold test kits before using them and should consult a professional mold testing service if they suspect mold in their homes.
Professional Mold Inspection and Testing
What to Expect from a Mold Inspector
A professional mold inspector is a trained and certified individual who inspects and tests homes, buildings, and other structures for mold. They use specialized equipment to detect mold growth and moisture levels. During a mold inspection, the inspector will visually examine the property for mold growth and water damage. They will also take air and surface samples to determine the type and concentration of mold present.
The inspector will provide a detailed report of their findings, including recommendations for remediation if necessary. They will also provide advice on how to prevent future mold growth. A professional mold inspection can take several hours, depending on the size of the property and the extent of the mold growth.
Accuracy of Professional Mold Testing
Professional mold testing is highly accurate and reliable, assuming that the mold testing company is reputable and qualified and has a strong track record of success in their community. Air mold tests are the most accurate way to determine exposure to mold in indoor environments. Tape lift tests can accurately determine if mold grows on a surface.
According to the National Association of Mold Remediators and Inspectors (NAMRI), a mold inspection report is a written evaluation prepared and issued by a residential mold inspector upon completion of a mold inspection that meets the standards of practice as established by NAMRI. The report should include a detailed description of the inspection process, the inspector’s findings, and recommendations for remediation if necessary.
Professional mold testing is essential in maintaining a safe and healthy home environment. Thorough evaluation of mold testing kits is necessary to make informed decisions. Over 80% of home mold test kits produce inaccurate results. It is therefore recommended to hire a professional mold inspector for accurate and reliable results.
Comparative Analysis: DIY Vs. Professional Testing

When it comes to testing for mold, homeowners have two options: DIY mold testing kits or professional mold inspections. While DIY mold testing kits offer a cost-effective and convenient option, professional mold inspections offer greater expertise, specialized equipment, and the ability to assess hidden areas.
Cost-Benefit Considerations
One of the biggest differences between DIY and professional mold testing is the cost. DIY mold testing kits are generally less expensive than professional mold inspections. However, it is important to consider the potential costs of not getting an accurate mold test. If a DIY mold test misses mold in your home, it could lead to health problems and costly repairs down the line. On the other hand, professional mold inspections can be more expensive but can save homeowners money in the long run by identifying mold problems early on.
Effectiveness and Reliability
When it comes to the effectiveness and reliability of mold testing kits, professional mold inspections are generally considered more accurate. Professional inspectors bring expertise, specialized equipment, and the ability to assess hidden areas, providing a more comprehensive assessment of mold in your home. DIY mold testing kits, on the other hand, may lack precision and accuracy. According to a Safe Home® article, “DIY mold testing kits may not provide the same level of accuracy as professional inspections, and may not be able to detect all types of mold.”
It is important to note that the reliability of mold test results can be affected by a number of factors, including the type of mold, the location of the mold, and the accuracy of the testing method used. Homeowners should carefully consider their options and choose the method that best fits their needs and budget.
In summary, while DIY mold testing kits offer a cost-effective and convenient option, professional mold inspections offer greater expertise, specialized equipment, and the ability to assess hidden areas. Homeowners should carefully consider the potential costs and benefits of each option before making a decision.
Identifying and Assessing Mold in Your Home

Mold is a type of fungus that can grow in damp and humid environments. It can cause various health issues, such as respiratory problems, headaches, and allergies. Therefore, it is essential to identify and assess mold in your home to prevent its growth and protect your health.
Visual Indicators and Health Symptoms
The most apparent sign of mold growth is visible mold on surfaces such as walls, ceilings, and floors. Mold can appear in different colors, such as black, green, or white. It can also have a fuzzy or slimy texture. If you notice visible mold growth, it is crucial to take action to remove it.
Another sign of mold growth is musty odors. If you notice a musty smell in your home, it may indicate mold growth in hidden areas such as behind walls or under carpets. In addition, mold can cause health symptoms such as coughing, sneezing, and itchy eyes. If you experience these symptoms, it is essential to identify and address the mold issue in your home.
When to Test for Mold
If you notice visible mold growth or musty odors in your home, it is recommended to test for mold. Testing can help identify the type and extent of mold growth in your home. It can also help determine the best course of action for mold removal.
It is also recommended to test for mold if you experience health symptoms that may be caused by mold exposure. However, it is important to note that not all health symptoms are caused by mold, and other factors such as allergies or respiratory infections can also cause similar symptoms.
In conclusion, identifying and assessing mold in your home is crucial for protecting your health and preventing mold growth. If you notice visible mold growth, musty odors, or health symptoms that may be caused by mold exposure, it is recommended to test for mold and take action to remove it.
Interpreting Test Results and Next Steps

Once you have received the results of your DIY mold test or professional mold inspection, the next step is to interpret the results and take appropriate action. This section will discuss how to understand the lab analysis and what steps to take for remediation and prevention.
Understanding Lab Analysis
If you have conducted a DIY mold test, you will receive a report that indicates the presence or absence of mold in your home. However, it is important to note that these tests are not always accurate and may not identify all types of mold present. Therefore, it is recommended to have a professional mold inspection for accurate results.
If you have received lab results from a professional mold inspection, the report will provide detailed information about the types and levels of mold present in your home. The report will also indicate whether the mold levels are within safe limits or require remediation.
It is important to note that not all types of mold are harmful, but some can cause serious health problems. Therefore, it is recommended to consult with a professional to determine the appropriate course of action.
Deciding on Remediation and Prevention
If the lab results indicate that mold levels are within safe limits, it is recommended to take preventative measures to avoid future mold growth. This may include improving ventilation, reducing humidity levels, and fixing any leaks or water damage.
If the lab results indicate that mold levels are above safe limits, remediation is necessary. Remediation involves removing the mold and addressing the underlying cause of the mold growth. This may include repairing water damage, improving ventilation, and reducing humidity levels.
It is important to note that mold remediation should be conducted by a professional to ensure that all mold is properly removed and the underlying cause is addressed. Failure to properly remediate mold can result in further health problems and damage to your home.
In conclusion, interpreting mold test results and taking appropriate action is crucial for maintaining a healthy living environment. By understanding the lab analysis and taking preventative measures or remediation when necessary, you can ensure that your home is safe and free from harmful mold growth.
The Role of Environmental Conditions in Mold Proliferation

Mold growth is a common problem in many households and can lead to significant health problems if left unchecked. The proliferation of mold is influenced by several environmental factors, including humidity, water damage, and poor ventilation. In this section, we will examine the impact of these factors on mold growth and how they can be managed to prevent mold growth.
Humidity, Water Damage, and Poor Ventilation
Humidity is a key factor in mold growth. High levels of humidity provide ideal conditions for mold spores to germinate and grow. The Environmental Protection Agency (EPA) recommends that indoor humidity levels be kept between 30% and 60% to prevent mold growth [1]. However, in areas with high humidity, such as bathrooms and kitchens, it may be necessary to use dehumidifiers or exhaust fans to maintain appropriate humidity levels.
Water damage is another significant contributor to mold growth. Leaks from pipes, roofs, and windows can provide a source of moisture for mold spores to grow. It is essential to address any water damage promptly and thoroughly to prevent mold growth. In cases of severe water damage, it may be necessary to hire a professional to remove any mold growth and repair the damage.
Poor ventilation can also contribute to mold growth. Areas with poor ventilation, such as basements and attics, can trap moisture and provide ideal conditions for mold growth. It is essential to ensure that these areas are adequately ventilated to prevent mold growth.
Maintaining Indoor Air Quality
Maintaining indoor air quality is crucial in preventing mold growth. HVAC systems can be a significant contributor to poor indoor air quality if not maintained correctly. Dirty filters and ducts can trap moisture and provide a breeding ground for mold spores. It is essential to have HVAC systems inspected and maintained regularly to prevent mold growth.
In addition to HVAC systems, indoor air quality can be improved by using air purifiers and regularly cleaning carpets and upholstery. These measures can help to remove mold spores and prevent their growth.
In conclusion, managing environmental conditions such as humidity, water damage, and poor ventilation is crucial in preventing mold growth. By maintaining appropriate humidity levels, addressing water damage promptly, ensuring proper ventilation, and maintaining indoor air quality, homeowners can prevent mold growth and protect their health.
[1] Environmental Protection Agency. (n.d.). Mold | US EPA. Retrieved from https://www.epa.gov/mold
Regulations and Standards for Mold Testing
When it comes to mold testing, there are various regulations and standards that must be followed to ensure compliance and safety. The Environmental Protection Agency (EPA) and the American Industrial Hygiene Association (AIHA) provide guidelines for mold testing to help ensure that accurate results are obtained.
EPA and AIHA Guidelines
The EPA has established guidelines for mold testing to ensure that individuals are not exposed to harmful levels of mold. The guidelines provide recommendations for mold testing in residential and commercial buildings. The EPA recommends that individuals hire a professional to conduct mold testing, as professionals have the necessary training and equipment to accurately test for mold.
The AIHA has also established guidelines for mold testing. The AIHA recommends that individuals use accredited laboratories to test for mold. Accredited laboratories are required to follow strict quality control procedures to ensure that accurate results are obtained.
Ensuring Compliance and Safety
To ensure compliance and safety, individuals should follow the guidelines established by the EPA and the AIHA when testing for mold. Individuals should also ensure that they are using the appropriate equipment and that they are properly trained to use the equipment.
It is important to note that mold testing can be dangerous if not done properly. Individuals should take appropriate safety precautions, such as wearing protective clothing and using respirators, when testing for mold.
In addition to following the guidelines established by the EPA and the AIHA, individuals should also be aware of any state or local regulations regarding mold testing. Some states have established regulations for mold testing, and individuals should ensure that they are in compliance with these regulations.
Frequently Asked Questions
What are the differences between professional mold testing and DIY mold test kits?
Professional mold testing involves a thorough inspection of your home by a certified mold inspector. They use specialized equipment to detect mold growth in hidden areas and collect samples for laboratory analysis. On the other hand, DIY mold test kits are designed for homeowners to collect samples themselves and send them to a lab for analysis. While professional mold testing is more expensive, it provides a more accurate and comprehensive assessment of your home’s mold situation.
How can you detect mold within your home’s walls?
Mold growth within your home’s walls is a common issue that can cause serious health problems if left untreated. Signs of mold growth include a musty odor, dampness, and discoloration of walls or ceilings. However, detecting mold within your walls can be difficult without professional equipment. A professional mold inspector can use thermal imaging cameras and moisture meters to detect mold growth within your walls.
What is the reliability of petri dish mold tests compared to professional methods?
Petri dish mold tests, also known as settle plate tests, are a common DIY method for detecting mold in the air. However, these tests are not as reliable as professional methods. Petri dish tests only capture a small sample of the air, and the results can be affected by factors such as air flow and temperature. Professional air mold tests use specialized equipment to capture a larger sample of the air and provide a more accurate assessment of mold levels.
What are the best practices for conducting an air mold test at home?
To conduct an air mold test at home, it is important to follow the instructions provided with the test kit carefully. Some general best practices include closing all windows and doors, turning off all fans and air conditioning units, and allowing the test to run for the recommended amount of time. It is also important to avoid disturbing the air during the test, as this can affect the accuracy of the results.
How can homeowners obtain a professional mold inspection, and what are the associated costs?
Homeowners can obtain a professional mold inspection by contacting a certified mold inspector in their area. The cost of a professional mold inspection varies depending on the size of the home, the extent of the mold growth, and the location of the mold. On average, a professional mold inspection can cost anywhere from $200 to $600.
Are there any home mold test kits that professionals consider accurate?
While there are a variety of home mold test kits available on the market, not all of them are considered accurate by professionals. Some of the most reliable home mold test kits include those that use air sampling cassettes or swabs to collect samples. However, it is important to note that even the most accurate home mold test kits may not provide a comprehensive assessment of your home’s mold situation.